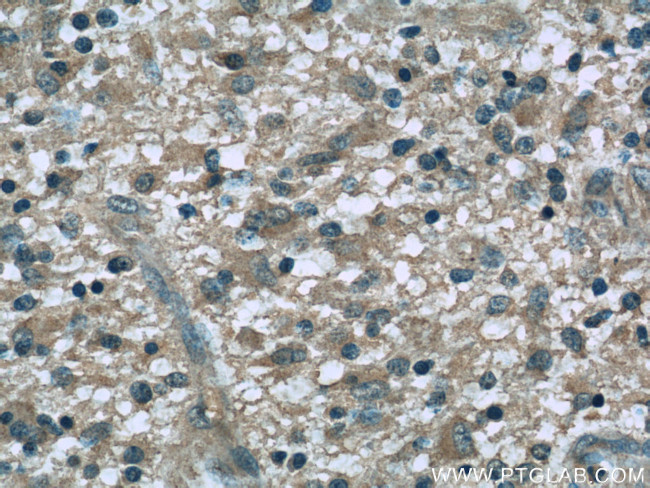
Dynamitin (1-401 AA) Antibody in Immunohistochemistry (Paraffin) (IHC (P))

Search
Proteintech
Dynamitin (1-401 AA) Monoclonal Antibody (2B9A5)
{{$productOrderCtrl.translations['antibody.pdp.commerceCard.promotion.promotions']}}
{{$productOrderCtrl.translations['antibody.pdp.commerceCard.promotion.viewpromo']}}
{{$productOrderCtrl.translations['antibody.pdp.commerceCard.promotion.promocode']}}: {{promo.promoCode}} {{promo.promoTitle}} {{promo.promoDescription}}. {{$productOrderCtrl.translations['antibody.pdp.commerceCard.promotion.learnmore']}}
产品信息
60257-1-IG
种属反应
宿主/亚型
分类
类型
克隆号
抗原
偶联物
形式
浓度
规格
纯化类型
保存液
内含物
保存条件
运输条件
产品详细信息
This antibody is against the N terminal 86aa of full length p50 dynamitin.
Immunogen sequence: MADPKYADL PGIARNEPDV YETSDLPEDD QAEFDAEELT STSVEHIIVN PNAAYDKFKD KRVGTKGLDF SDRIGKTKRT GYESGEYEML GEGLGVKETP QQKYQRLLHE VQELTTEVEK IKTTVKESAT EEKLTPVLLA KQLAALKQQL VASHLEKLLG PDAAINLTDP DGALAKRLLL QLEATKNSKG GSGGKTTGTP PDSSLVTYEL HSRPEQDKFS QAAKVAELEK RLTELETAVR CDQDAQNPLS AGLQGACLME TVELLQAKVS ALDLAVLDQV EARLQSVLGK VNEIAKHKAS VEDADTQSKV HQLYETIQRW SPIASTLPEL VQRLVTIKQL HEQAMQFGQL LTHLDTTQQM IANSLKDNTT LLTQVQTTMR ENLATVEGNF ASIDERMKKL GK (1-401 aa encoded by BC014083)
靶标信息
This gene encodes a 50-kD subunit of dynactin, a macromolecular complex consisting of 10-11 subunits ranging in size from 22 to 150 kDa. Dynactin binds to both microtubules and cytoplasmic dynein. It is involved in a diverse array of cellular functions, including ER-to-Golgi transport, the centripetal movement of lysosomes and endosomes, spindle formation, chromosome movement, nuclear positioning, and axonogenesis. This subunit is present in 4-5 copies per dynactin molecule. It contains three short alpha-helical coiled-coil domains that may mediate association with self or other dynactin subunits. It may interact directly with the largest subunit (p150) of dynactin and may affix p150 in place.
仅用于科研。不用于诊断过程。未经明确授权不得转售。
生物信息学
蛋白别名: 50 kD dynactin subunit; 50 kDa dynein-associated polypeptide; DCTN-50; dynactin 2 (p50); Dynactin complex 50 kDa subunit; Dynactin subunit 2; epididymis secretory protein Li 77; epididymis secretory sperm binding protein; GMP23-48K; Growth cone membrane protein 23-48K; p50 dynamitin; unnamed protein product
基因别名: 2310042E05Rik; C130077D06Rik; C87049; DCTN-50; DCTN2; DCTN50; DYNAMITIN; GMP23-48K; HEL-S-77; p50; RBP50
UniProt ID: (Human) Q13561, (Mouse) Q99KJ8
Entrez Gene ID: (Human) 10540, (Mouse) 69654